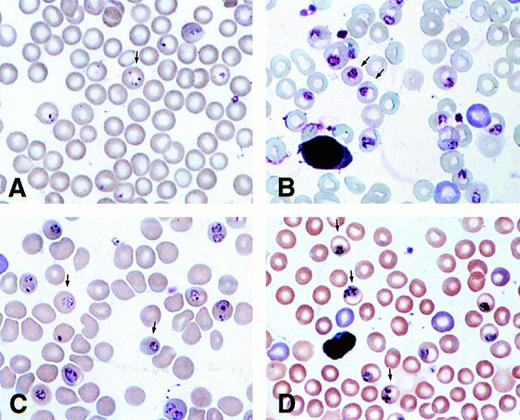
Fig. 4. Blood smears of γ (A and B) and normal (C and D) mice infected with P chabaudi adami taken at 10:30 am (A and C) and 6:30 pm (B and D).

Abstract
Studies in vitro by Pasvol et al (Nature, 270:171, 1977) have indicated that the growth of Plasmodium falciparum in cells containing fetal hemoglobin (HbF = α2γ2) is retarded, but invasion is increased, at least in newborn cells. Normal neonates switch from about 80% HbF at birth to a few percent at the end of the first year of life. Carriers of β-thalassemia trait exhibit a delay in the normal HbF switch-off, which might partially explain the protection observed in populations with this gene. To study this hypothesis in vivo, we used transgenic (γ) mice expressing human Aγ and Gγ chains resulting in 40% to 60% α2Mγ2 hemoglobin, infected with rodent malaria. Two species of rodent malaria were studied.P chabaudi adami causes a nonlethal infection, mainly in mature red blood cells (RBC). P yoelii 17XNL is a nonlethal infection, invading primarily reticulocytes, whereas P yoelii 17XL is a lethal variant of P yoelii 17XNL and causes death of mice in approximately 1 to 2 weeks. Data indicate that this strain may cause a syndrome resembling cerebral malaria caused by P falciparum (Am J Trop Med Hyg, 50:512, 1994). In γ transgenic mice infected with P chabaudi adami, the parasitemia rose more quickly (in agreement with Pasvol) than in control mice, but was cleared more rapidly. In mice infected with P yoelii 17XNL, a clear reduction in parasitemia was observed. Interestingly, splenectomy before this infection, did not reverse protection. The most striking effect was in lethal P yoelii17XL infection. Control mice died between 11 to 13 days, whereas γ mice cleared the infection by day 22 and survived, a phenomenon also observed in splenectomized animals. These results suggest that HbF does indeed have a protective effect in vivo, which is not mediated by the spleen. In terms of mechanisms, light microscopy showed that intraerythrocytic parasites develop slowly in HbF erythrocytes, and electron microscopy showed that hemozoin formation was defective in transgenic mice. Finally, digestion studies of HbF by recombinant plasmepsin II demonstrated that HbF is digested only half as well as hemoglobin A (HbA). We conclude that HbF provides protection from P falciparum malaria by the retardation of parasite growth. The mechanism involves resistance to digestion by malarial hemoglobinases based on the data presented and with the well-known properties of HbF as a super stable tetramer. In addition, the resistance of normal neonates for malaria can now be explained by a double mechanism: increased malaria invasion rates, reported in neonatal RBC, will direct parasites to fetal cells, as well as F cells, and less to the ≈20% of HbA containing RBC, amplifying the antimalarial effects of HbF.
THE HUMAN GENOME has been modified to a remarkable degree by the malaria parasite. Several well-known polymorphisms of hemoglobin, including S, C, and E, as well as glucose 6 phosphate dehydrogenase (G6PD) deficiency, have been linked to areas of prevalence of Plasmodium falciparum (reviewed in Nagel and Roth1). These associations, originally demonstrated by epidemiologic data, were later confirmed by experiments in vitro in which the parasite was observed2 or grown3 in variant erythrocytes. Thus, the mechanism of resistance of AS red blood cells (RBC) was partially explained by “suicidal invasion” and by the fact that the parasites do not develop as well in AS cells when exposed to low O2tension.4-6 However, further insight into the mechanism of protection of sickle hemoglobin (HbS) was obtained through the use of transgenic mice expressing varying levels of HbS and infected with different species of rodent malaria.7 8
The association between α and β thalassemia and areas of malaria prevalence, while not as strong as for the sickle gene, is also significant.1,9,10 Inasmuch as the switch from fetal to adult hemoglobin is delayed in β thalassemia,10 it has been hypothesized that, in part, β-thalassemia affords protection from dying of malaria by increases in intracellular fetal hemoglobin (HbI).11 12 Additional evidence for a role for HbF is the finding that newborns are less susceptible to P falciparum.11
Studies in vitro have indicated that P falciparum invades RBC containing HbF normally,12 but that their development is diminished.11,12 However, the mechanism whereby HbF might inhibit the growth of the parasite has remained obscure, although oxidative stress damage has been mentioned.13
Recently, several lines of transgenic mice expressing humanGγ and Aγ have been developed in our laboratory.14 In the current study, these mice have been infected with several different species and strains of rodent malaria: two species of nonlethal malaria, P chabaudi adami and P yoelii 17XNL and one the virulent strain, P yoelii 17XL, which causes a syndrome resembling human cerebral malaria.15
MATERIALS AND METHODS
Animals.
C57BL/6J female mice, 6 to 8 weeks old, were obtained from the Jackson Laboratories (Bar Harbor, ME). Swiss Webster mice (female, 6 to 8 weeks old) were from Taconic Farms (Germantown, NY). Development of the transgenic mice was described previously.14 In brief, an HS4-Gγ-γA construct HS4 (951-2204 of Genbank file HUMHBB) was linked to the BglIII-Nhe I fragment (32837-43203) that includes Gγ (−158T),Aγ, and the 3′ enhancer. Two transgenic lines were obtained that expressed γ globin. Transgenic line 13 had 40 to 50 copies of the construct. Transgenic mice were mated to C57BL/6J mice to obtain the developmental patterns of %γ and Gγ:Aγ ratios of line 13 heterozygotes. One of the mouse lines was bred into a mouse βMajor deletion line and progenies expressing 40% to 60% (α2Mγ2) hemoglobin were obtained. Mice were bred at the Albert Einstein College of Medicine in an American Association of Accredited Animal Care–accredited facility. Oxygen equilibrium of the RBC, done with methods described elsewhere,16 16ademonstrates a p50 of 24.9 mm Hg, considerably lower than that of the parental C57BL/6J mouse, with a p50 of 40 mm Hg under the same conditions. This is compatible with the presence of a majority of tetramers (α2M/γ2 or α2M/βγ) not capable of binding 2,3 diphosphoglycerol (2,3 DPG). Further proof of this phenomenon is a lower RBC 2,3 DPG level (28.3 ± 2.5 μg/pgHb) in the γ mouse, compared with 31 μg/pgHb found in normal mice, the consequence of slight end product inhibition due to the increase in free 2,3 DPG.17
(A) Course of P chabaudi adamiinfection in C57BL/6J controls (○; n = 5) and transgenic mice expressing 40% to 60% α2Mγ2hemoglobin (•; n = 4). Mice were infected intraperitoneally with 1 × 105 infected erythrocytes on day 9. (B) Mice were injected with 5 × 105 infected erythrocytes on day 0. On the days indicated, smears were prepared from the tail vein, stained, and counted. Data are expressed as mean parasitemia ± standard error of mean (SEM).
(A) Course of P chabaudi adamiinfection in C57BL/6J controls (○; n = 5) and transgenic mice expressing 40% to 60% α2Mγ2hemoglobin (•; n = 4). Mice were infected intraperitoneally with 1 × 105 infected erythrocytes on day 9. (B) Mice were injected with 5 × 105 infected erythrocytes on day 0. On the days indicated, smears were prepared from the tail vein, stained, and counted. Data are expressed as mean parasitemia ± standard error of mean (SEM).
The globin composition was determined by high performance liquid chromatography (HPLC) using a denaturing solvent that separates the globin chains and a Vydac large-pore (300A) C4 column, 4.6 × 250 mm (Separations Group, Hesperia, CA) with a modified acetonitrile/H2O/trifluoroacetic acid (TFA) gradient similar to that used by Schroeder et al18 for separating human globin chains. Two buffers were used, A (0.18% TFA in 36% acetonitrile) and B (0.18% TFA in 46% acetonitrile). Starting with 38% B, the percent B was increased by 0.583%/minute until all of the globin chains were eluted.
(A) Course of P yoelii 17XNL (nonlethal) infection in intact (•; n = 2) and splenectomized (▪; n = 3) transgenic mice expressing 40% to 60% α2Mγ2 hemoglobin. Mice were infected intraperitoneally with 1 × 105 infected erythrocytes on day 0. On the days indicated, smears were prepared from the tail vein, stained, and counted. Data are expressed as mean parasitemia ± SEM. (B) Course of P yoelii 17XNL infection in C57BL/6J intact (○; n = 6) and splenectomized controls (□; n = 4). Mice were infected intraperitoneally with 1 × 105 infected erythrocytes on day 0. On the days indicated, smears were prepared from the tail vein, stained, and counted. Data are expressed as mean parasitemia ± SEM.
(A) Course of P yoelii 17XNL (nonlethal) infection in intact (•; n = 2) and splenectomized (▪; n = 3) transgenic mice expressing 40% to 60% α2Mγ2 hemoglobin. Mice were infected intraperitoneally with 1 × 105 infected erythrocytes on day 0. On the days indicated, smears were prepared from the tail vein, stained, and counted. Data are expressed as mean parasitemia ± SEM. (B) Course of P yoelii 17XNL infection in C57BL/6J intact (○; n = 6) and splenectomized controls (□; n = 4). Mice were infected intraperitoneally with 1 × 105 infected erythrocytes on day 0. On the days indicated, smears were prepared from the tail vein, stained, and counted. Data are expressed as mean parasitemia ± SEM.
Infection with rodent malaria parasites.
P chabaudi adami, P yoelii 17XL (lethal) and 17XNL (nonlethal) stored in liquid nitrogen, were used to infect source mice. Experimental mice were infected by intraperitoneal inoculation of 1 × 105 or 5 × 105 erythrocytes obtained from a source mouse. Parasitemia was monitored by making smears of blood obtained from the tail vein and counting 50 Giemsa-stained fields or at least 300 RBC under oil immersion (1,000×). Some slides were also evaluated for parasite stage by examining 200 infected erythrocytes per slide. The statistical significance of the data was assessed by comparing mean parasitemia of groups of mice at specific time points using the Student's t-test.
Electron microscopy.
Blood was obtained from control and transgenic mice at 10:30am and 6:30 pm and fixed in phosphate-buffered saline (PBS) containing 2.5% glutaraldehyde.
Digestion of HbF by plasmepsin II.
A total of 60 mL of HbF and HbA, at 0.5 g/dL were incubated with 2, 4, and 6 μL recombinant plasmepsin II in a citrate-phosphate buffer, pH 5.0 in a water bath at 37°C for 4 hours.19 20 The control received addition of a saline solution. Digestion was stopped by freezing in liquid N2. Analysis was conducted on a C4− HPLC column on 1,000 μL 0.3% TFA + 20 μL of the Hb digest. The injection volume was 900 μL, and it was developed with a gradient of 5% to 50% in acetonitrile of 0.1% TFA over 130 minutes. The graphic output was used to identify the peak of intact hemoglobin (that was confirmed by mass spectrophotometry). The areas under the curve were compared for each digestion point. The peak, in the absence of digestion, was used to standardize the 100% point.
RESULTS
Course of P chabaudi adami infection in transgenic mice expressing high levels of human Aγ and Gγ chains.
Transgenic and C57BL/6 control mice were injected intraperitoneally with erythrocytes infected with P chabaudi adami. This parasite preferentially invades mature RBC. In Fig 1A, mice were injected with 1 × 105 infected RBC. Parasitemia rose more quickly in the transgenic mice than in controls. However, the infection was also cleared more rapidly in the transgenics. In Fig 1B, this experiment was repeated, but mice were infected with 5 × 105 infected RBC. The same pattern of infection was observed. On day 7, parasitemia was significantly higher in transgenic as compared with control mice (P < .05). However, parasitemias of both groups were higher and peak parasitemia of the control mice was higher than that of the transgenic mice. In these experiments, the level of reticulocytosis was increased in both transgenic and control mice, from 4% to 5% in noninfected mice to 12% on day 12. Of these reticulocytes, however, only 10% to 20% were infected. Thus, most of the parasites were in mature RBC.
Course of P yoelii 17XNL in transgenic mice and effect of splenectomy.
Because P chabaudi adami infects mainly mature RBC, whereasP yoelii 17XNL infects mainly reticulocytes, we infected transgenic and control mice with P yoelii 17XNL. The results of this experiment are shown in Fig 2A and B. Although peak parasitemia was reached on the same day in both groups, the level of peak parasitemia was much lower in transgenic mice (16%) as compared with controls (38%). Furthermore, transgenics had cleared the infection by day 24, whereas infection in controls continued to increase.
Prior studies with transgenic mice expressing βSindicated that the spleen played a major role in protection of these mice.7 We therefore determined whether splenectomy would reverse the protection observed in the γ mice. In both transgenics and control mice, splenectomy initially protected the animals. However, in both groups of splenectomized mice, parasitemia eventually climbed to the levels experienced by intact mice (not shown).
Infection of transgenic mice with lethal malaria.
Our recent studies indicate that the lethal form of P yoelii(17XL) causes a syndrome similar in some aspects to cerebral malaria in humans.15 Transgenic mice expressing βS are protected from this form of malaria. To determine whether γ mice were also protected from this strain, we infected γ mice and controls with this parasite. Remarkably, the transgenic γ mice recovered from this otherwise lethal infection (Fig 3). Like P falciparum, this parasite can invade both mature and immature RBC. Thus, the parasites are usually found in mature erythrocytes, as reticulocytes are not elevated, initially. However, in γ mice, which eventually recovered, some parasites were found in reticulocytes. For example, on day 9, 1% to 5% of blood cells were reticulocytes and 70% ± 23% of these were parasitized, whereas in control mice, there were less than 1% reticulocytes and close to 100% of the parasites were in mature RBC. This is similar to our findings in transgenic mice expressing βS, which recovered from this infection.8 This experiment was repeated with identical results.
Course of P yoelii 17XL (lethal) infection in C57BL/6J controls (○; n = 6) and transgenic mice expressing 40% to 60% α2Mγ2 hemoglobin (•; n = 7). Mice were infected intraperitoneally with 1 × 105 infected erythrocytes on day 0. On the days indicated, smears were prepared from the tail vein, stained, and counted. Data are expressed as mean parasitemia ± SEM.
Course of P yoelii 17XL (lethal) infection in C57BL/6J controls (○; n = 6) and transgenic mice expressing 40% to 60% α2Mγ2 hemoglobin (•; n = 7). Mice were infected intraperitoneally with 1 × 105 infected erythrocytes on day 0. On the days indicated, smears were prepared from the tail vein, stained, and counted. Data are expressed as mean parasitemia ± SEM.
Development of intraerythrocytic parasites in RBC expressing γ chains.
Because the mechanism of protection of γ mice did not appear to be via splenic clearance, we considered the possibility that the parasites did not develop normally in erythrocytes expressing HbF. Blood smears, taken in the morning and evening, indicated that the parasites develop more slowly in RBC of γ mice. Figure 4A and C show blood smears taken at 10:30 am from a γ transgenic (Fig4A) and a normal C57/BL6J (Fig 4C) mouse. The γ mouse has mainly early ring stages, whereas the normal mouse has more mature trophozoites. At 6:30 pm, parasites in the γ transgenic mouse had only matured to large trophozoites (Fig 4B), while parasites in the normal mouse were mainly early schizonts (Fig 4D). A quantitative assessment of stages in the blood smears is shown in Fig5.
Blood smears of γ (A and B) and normal (C and D) mice infected with P chabaudi adami taken at 10:30 am (A and C) and 6:30 pm (B and D).
Blood smears of γ (A and B) and normal (C and D) mice infected with P chabaudi adami taken at 10:30 am (A and C) and 6:30 pm (B and D).
Stages of intraerythrocytic parasites (P chabaudi adami) found in blood smears taken at 10:30 am (□) and 6:30 pm (▪) (200 infected erythrocytes on four smears were counted. Data represent mean ± SEM).
Stages of intraerythrocytic parasites (P chabaudi adami) found in blood smears taken at 10:30 am (□) and 6:30 pm (▪) (200 infected erythrocytes on four smears were counted. Data represent mean ± SEM).
Erythrocytes were fixed for electron microscopy at the same time points as the blood smears were taken. The results (Fig 6) indicated that little hemozoin was present in HbF (Fig 6A), trophozoite, and (Fig 6B) schizont. Further, the hemozoin was not in food vacuoles. In contrast, in normal erythrocytes, there was more hemozoin and it was present in discreet vacuoles (Fig 6C) trophozoite (Fig 6D) schizont.
Electron micrographs of γ (A and B) and normal (C and D) mice infected with P chabaudi adami taken at 10:30am (A and C) and 6:30 pm (B and D).
Electron micrographs of γ (A and B) and normal (C and D) mice infected with P chabaudi adami taken at 10:30am (A and C) and 6:30 pm (B and D).
Digestion of HbF by plasmepsin II.
We assayed digestion of human HbA and HbF with recombinant plasmepsin II of P falciparum. An experiment using rodent hemoglobin was not possible because plasmepsin II has not been cloned from a rodent parasite. The digestion by plasmepsin II of a solution of 0.5 g/dL of either HbA or HbF, with three concentrations of enzyme for 4 hours (Fig7) demonstrates that the enzyme digests HbA more readily than HbF. Further, the extent of digestion is enzyme-concentration–dependent. Thus, plasmepsin II digests HbA about twice as well as HbF.
Digestion of HbF and HbA by recombinant plasmepsin II as in Materials and Methods. y-axis represents the percent digestion: x-axis, μg of enzyme.
Digestion of HbF and HbA by recombinant plasmepsin II as in Materials and Methods. y-axis represents the percent digestion: x-axis, μg of enzyme.
DISCUSSION
Our laboratory has used transgenic mice expressing variant human hemoglobins to analyze the roles of these mutations in protection against malaria.7 8 These animal models allow the study of the effect of hemoglobinopathies on the host parasite interaction in vivo. The studies reported here used rodent malarias of varying virulence and erythrocyte preference to gain insight into the mechanism of protection by HbF.
In the current studies, we used transgenic mice expressing humanGγ and Aγ chains. Previously, Pasvol et al6 suggested that HbF was protective against falciparum malaria, based on in vitro observations. The protection was found to be mediated by the presence of HbF and not by the age or source of RBC. However, the protective mechanism was not defined. Friedman13 suggested that the protection was mediated by increased sensitivity of the HbF containing erythrocytes to oxidant stress, as parasite growth in the absence of glutathione was inhibited.
Our first results indicated that HbF was somewhat protective againstP chabaudi adami, but less so than βS.7 Our results, in terms of the effect of erythrocyte age, confirmed those of Pasvol,12 in that invasion appeared to be enhanced, but growth of the parasites was diminished. Enhanced invasion coupled with poor development may have led to the early decline of parasitemia in the transgenic mice. In addition, we found that splenectomy did not reverse the protection mediated by HbF as it did in βS mice. Thus, the protection mediated by HbF may not be due to changes in the ability of the erythrocytes to be recognized by the spleen (one of the mechanisms by which HbS protects), but rather, due to properties of the RBC containing human fetal globin for which the spleen was insensitive.
Our results suggest that malaria parasites may not develop normally in erythrocytes containing HbF because the parasites cannot digest this hemoglobin as well as HbA. This leads to a delay in development of the parasite. Morphologically, this was apparent in the difference in blood stages at early and later time points, between normal and transgenic mice. Moreover, electron microscopy demonstrated that hemozoin is not synthesized normally in the γ mice. Similar results were reported forP falciparum grown in β-thalassemic RBC in medium deficient in essential amino acids, particularly in those containing HbF.21 22 Finally, the rate of digestion of HbF by a recombinant malarial human hemoglobinase is approximately half that of HbA. Taken together, these results provide a mechanism for the ability of HbF to protect the host from the lethality of malaria.
The biochemistry of human HbF (reviewed in Nagel23) demonstrates that this normal hemoglobin differs with HbA in several properties: it dissociates into dimers with more difficulty and it does not bind 2,3 DPG well. Even more importantly, it is significantly more acid- and alkaline-resistant and it is more heat stable. In addition, HbF resists conversion into methemoglobin and loses the heme moiety with difficulty compared with HbA. These last features of HbF are very important, because the alimentary vacuole of the plasmodium parasite has a pH estimated to be about pH 5.0, which in itself, will result in partial or complete loss of heme and considerable loss of the tetrameric, tertiary, and secondary structure. The plasmepsins make their initial cleavage in the hinge region at the dimer interface of hemoglobin.24,25 Access to this region almost certainly requires dissociation into dimers. HbF will be a less willing subject of denaturation. In effect, all of the properties outlined above point to a more stable and stronger hemoglobin tetramer in HbF than in HbA. These properties reside entirely in the γ chains with no known contribution by the α chains. That some of these properties, if not all, are present in the mouse RBC are demonstrated by the observed change in oxygen equilibrium, which is the one expected if the binding of 2,3 DPG is greatly diminished.17
Our results indicate that HbF or tetramers containing Gγ and Aγ chains are partially resistant to digestion by the parasite's proteolytic machinery, hampering the capacity of the parasite to grow.
This might occur in the circulation or the internal organs and might not be as dependent on the spleen for recognition of membrane changes. In this study, we found that splenectomy actually protected both transgenic and control mice. In mice, the spleen is a hematopoietic organ.26 In the absence of the spleen there may be fewer reticulocytes, the preferred host cell of P yoelii 17XNL, produced. Sayles et al27 have also found that splenectomy protects mice infected with P yoelii 17XNL. They suggested that this may be due to changes in antibody specificities and class.28 On the other hand, in transgenic mice espressing βS, membrane changes may be sufficient to mediate splenic clearance and, therefore, splenectomy reverses protection.7
It is most interesting that HbF mice were protected against the lethal form of P yoelii (17XL). This is consistent with observations on human malaria, which suggest that greater effects of resistance alleles are seen in severe disease.29 HbF mice not only had lower parasite densities, but recovered from a usually lethal infection.
The observed increase in invasion rates in neonatal human RBC, coupled with a decrease in growth, might render the effect of HbF significantly amplified. HbF is distributed among RBC heterogeneously. In the blood of the neonate, it is limited to fetal cells (large fetal cells with 100% HbF) and F cells (smaller adult cells with a variable, but significant amount of HbF). Higher invasion rates of fetal and F cells will tend to concentrate the parasites in the cells that unfortunately for the parasite are less hospitable, those cells carrying the unpalatable HbF. In β-thalassemia, the protection towards malaria based on HbF, will linger much longer than in normal individuals and extend to the better part of the first 5 years of life, as the amount of HbF per cell and the number of F cells are higher than normal.
We conclude that mouse RBC containing fetal globin protect the host from rodent malaria and the effect is maximum, with the lethal and cerebral malaria inducing strain of growth through ineffective digestion of their only source of sustenance: hemoglobin.
ACKNOWLEDGMENT
The technical help of Nazim Fataliev in the digestion of the hemoglobins with plasmepsin II is gratefully acknowledged.
Supported by Grants No. AI 34064 to H.L.S., HL 38655 to R.L.N., and AI 31615 to D.E.G. from the National Institutes of Health, Bethesda, MD.
Address reprint requests to Hannah L. Shear, PhD, Division of Hematology, Montefiore Medical Center, 111 East 210th St, Bronx, NY 10467.
The publication costs of this article were defrayed in part by page charge payment. This article must therefore be hereby marked "advertisement" is accordance with 18 U.S.C. section 1734 solely to indicate this fact.

This feature is available to Subscribers Only
Sign In or Create an Account Close Modal